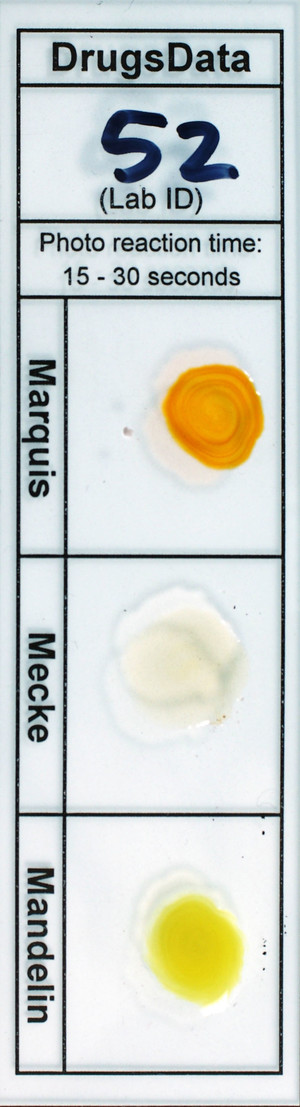
Detail Photo

New Submissions Are Not Currently Being Accepted
Samples sent after April 10, 2024 will be put on hold.
Viewing desktop version: Switch to Mobile
Tina
Sold as: Methamphetamine
ID: 9675
Sold as: Methamphetamine
Expected to be: Methamphetamine

BTNX Fentanyl Test Strip (prior to sending in sample): Negative